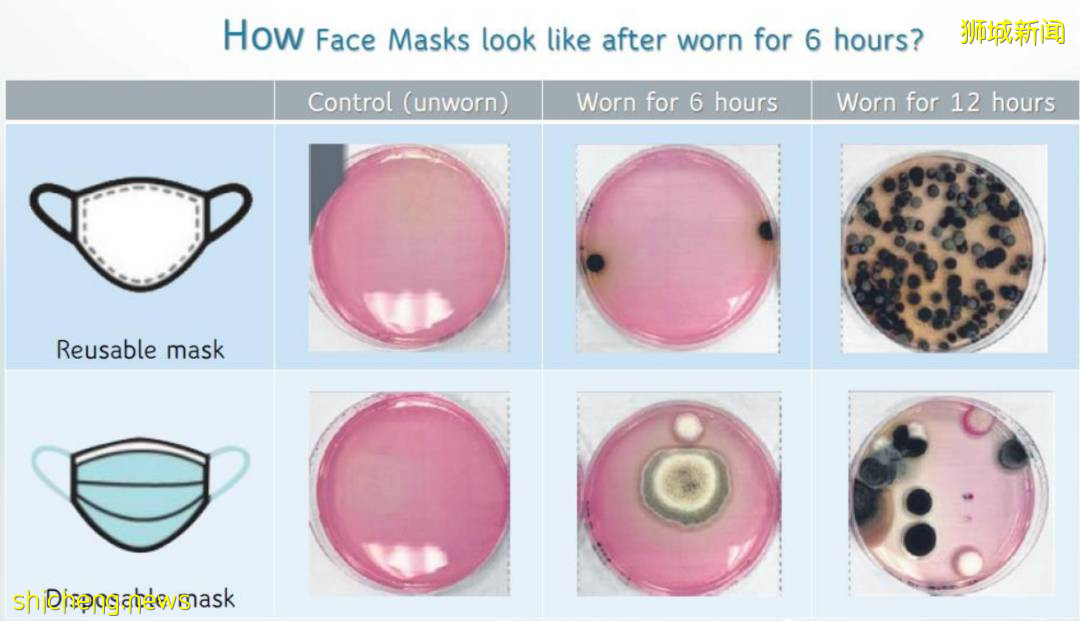
新加坡病例飙升下,1万6500确诊者在家养病!必备“生存包”来了

新加坡病例飙升下,1万6500确诊者在家养病!必备“生存包”来了
自从李显龙总理全国演讲之后,很多人都接受了“现实”。
新加坡真的要与新冠坚定共存了,根据卫生部的每日汇报,现在至少有1.65万人,77%的确诊者进行居家康复。

*绿色为每日居家康复人数
这些人是你是熟人、邻居、同事。

而居家康复最快7-10就能解除隔离,密切接触者快速检测呈阳性就能出门。
所以现在普通人被感染的几率也变大了,大家只能保护好自己。
这几样必不可少的东西
01 温度计
对于出现症状的人,往往还是会伴随发烧,所以请准备好温度计,在怀疑自己生病时检查体温。

02 血氧仪
如果你不能分辨自己是普通感冒还是新冠,用血氧仪检查血液中的氧气水平,可以帮助发现健康恶化的早期迹象。
- 血氧水平在95%至100%之间被认为是健康的
- 90%至94%的水平被认为是低的。
- 血氧水平低于90%是 "危险" 但是注意血氧低只能说明你应尽快就医,不等于就是确诊了,特别对于一些有慢性病的人来说血氧低可能是其他原因。

03 抗原快速检测(ART)试剂盒
建议家里每个人至少要有两个ART自测仪器,注意不同品牌的说明和操作会有所不同,每次使用前务必仔细阅读说明。
丢弃这些检测试剂盒中,务必使用双层塑料袋密封,以免让病毒通过垃圾传播。
04 家庭清洁、消毒用品
即使家里没有成员感染,也建议常备消毒用品,如果有人确诊那就必不可少了。
每个家庭都应配备洗手液、肥皂、消毒湿巾和漂白剂等消毒剂。经常自我清洁和擦拭共用的厕所或其他物品表面至关重要。
05 口罩
随着Delta和Lambda变种等新毒株的兴起,人们对口罩的选择更加谨慎。
作为一天中大部分时间陪伴你的必需品,口罩就像是你的第二层皮肤。

特别是对于那些需要外出工作,或照顾家庭和亲人的人来说,口罩更是“最后一道防线”。

一个高质量的口罩是对幸福和安心的投资。
有国际认证的知名外科口罩的供应商Callie,推出了一种创新的新产品,可以说是“新一代的Covid杀手”

Callie的新作品名为 Quantum Supreme Beige (量子至尊米色),是一种尖端技术的自我消毒口罩。
这款口罩区别于普通医用口罩之处在于, 上面有量子共振铜(QR-C)涂层。这种涂层应用于口罩的外表面,使用专有的量子共振频率,有效地分解和氧化落在口罩上的病毒、细菌和微生物等病原体。
*穿戴普通口罩6小时后 传统的外科口罩,病原体也可能在接触后残留在口罩表面;
如果佩戴者再接触脸部的任何部位、揉眼睛或一般不适当地处理口罩,他们就有被感染的风险。

*QR-C涂层的作用原理
这种创新的新口罩不但有Callie所擅长的高质量口罩的所有保护能力,而且具有在接触后一分钟内杀死高达99.99%的SARS-COV-2病原体的额外能力。
Callie的Quantum Supreme Beige口罩减少了因口罩处理不当而感染的机会,
而且具有防臭、抗菌和抗病毒的特性,可显著提高个人安全。
Quantum Supreme Beige口罩通过马来西亚大学的实验室的检测。

马来西亚生产的Callie四层医用口罩早已经风靡大马,很多官员和网红都在佩戴。
马来西亚交通部长魏家祥





网红小姐姐们最爱颜色淡雅,柔软舒适的Callie口罩


让网红们对Callie口罩趋之若鹜的原因,除了高性能之外,还有高颜值~

很多人因为长期戴口罩,闷痘严重,特别是敏感肌肤戴口罩,脸和脖子都磨得疼。
Callie的口罩精心选择原选材,柔软舒适,确保足够的亲肤度。 Quantum Supreme Beige



现在这款高颜值、高性能的口罩已在新加坡热商城上架
Callie 四层医用量子口罩 自动消毒 (成人) 至尊肤色 一盒50片 优惠价$21.00 长按扫码购买


• 量子共振铜(QR-C)涂层,1分钟杀灭99.99%病毒 • 防臭、抗菌和抗病毒 • 消除大多数落在口罩表面的病原体 • 50片 4层外科级口罩,具有高达 99% 的亚微米保护 • 舒适、透气的设计 • 通过 MDA、FDA 和 CE 批准 • 马来西亚制造并通过 ISO 13485:2016 认证 • 面罩尺寸:175mm x 95mm • 达到并超过 ASTM F2100:2019(1、2 和 3 级)
生产商Rentas Health Sdn Bhd
代理商Capital S Pte Ltd
Callie品牌口罩
已经入驻热商城
还有多款彩色四层医用口罩可选!

儿童款也非常可爱清爽!

批发联系电话 9088 8191
最近新加坡病例飙升个人防护最重要,生活用品容易找,关键时期的防疫用品得上哪里买?
在新加坡热商城的“防疫产品”板块,你可以找到如洗手液和自助检测仪等产品,快来看一看吧

长按扫码浏览商品

评论